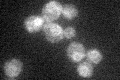
YJL192C
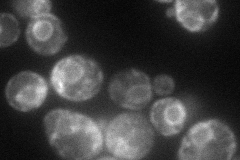
YJL192C

View description
ER-membrane protein; suppressor of pma1-7, deletion of SOP4 slows down the export of wild-type Pma1p and Pma1-7 from the ER
Localization:
Intensity:
Fold change:
Significance:
-
C’ GFP library in SD
ER26.74 -
N' NOP1pr-GFP in SD
ER70.9832 -
N' TEF2pr-mCherry in SD

ER16.7361 -
N' NATIVEpr-GFP in SD

ER27.3728 -
N' TEF2pr-VC and Cyto-VN in SD

#N/A0 -
C’ GFP library in SD+DTT

ER23.780.88No -
C’ GFP library in SD+H2O2

ER30.151.12No -
C’ GFP library in Starvation Media

ER22.120.82No -
C’ GFP library on the background of Pup2-DaMP

ER -
C’ GFP library on the background of CCT mutant

ER30.62271.14474No
